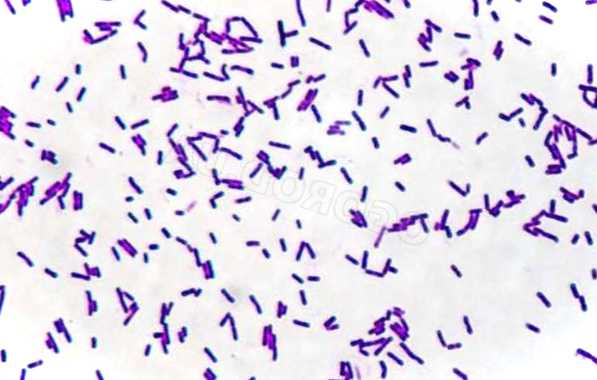

Як і де застосовується бактеріальна культура


Сінна паличка, що має наукову назву Bacillus subtilis, є спороутворюючим рухомим паличкоподібним грампозитивним факультативним аеробом. В основному він міститься в ґрунті та рослинності, і має оптимальну температуру зростання 25-35 градусів за Цельсієм. Сінна паличка як на фото має здатність виробляти і секретувати багато ферментів, і з цією метою використовується в промислових масштабах біотехнологічними компаніями для обробки насіння, овочів та рослин як фунгіцид.
Властивості та патогенність
Геномна структура цього мікроорганізму містить п'ять генів сигнальних пептидаз, які є важливими для секреції зазначених речовин. Доведено, що B. subtilis здатна секретувати поліміксин, диффіцидин, субтилін та мікобацилін. Ці ферменти синтезуються під час споруляції, збільшуючи шанси мікроорганізму на виживання і одночасно знищує конкуруючі мікроби.
Сінна паличка (на фото під мікроскопом) вважається безпечною для здоров'я, проте в деяких випадках може заражати їжу і ставати умовно-патогенним мікроорганізмом для людей з ослабленим імунітетом. У природі найчастіше вона мешкає в кореневій системі рослин, перешкоджаючи розмноженню хвороботворних мікроорганізмів. Деякі штами сінної палички здатні виробляти токсини, небезпечні для комах-шкідників, та застосовуються деякими фермерами для захисту врожаю.
Як здійснюється розмноження та культивування

Bacillus subtilis здатна до поділу одночасно двома способами:
- симетрично з утворенням двох дочірніх клітин (так званий бінарний поділ);
- асиметрично з формуванням однієї ендоспори, що зберігає життєздатність протягом десятиліть, і має стійкість до несприятливих зовнішніх впливів (посуха, високий рівень солі, не збалансований pH, радіація та хімічні забруднення).
Будова бактерії сінної палички
Ендоспори утворюються за рахунок гідролізу, що дозволяє мікроорганізму зберігатися життєздатним до покращення навколишніх умов. До початку споруляції клітини сінної палички іноді набувають рухливості, поглинаючи ДНК із навколишнього середовища або виробляючи ферменти. Такі реакції вважаються спробами отримати поживні речовини або знайти сприятливіші зовнішні умови за рахунок використання чужого генетичного матеріалу або знищення інших мікроорганізмів, що становлять конкуренцію.
В екстремальних умовах (насамперед, нестачі поживних речовин), сінна паличка починає процес спороношення. Цей механізм на сьогоднішній день ретельно вивчений і використовується для штучного культивування бактерії сінної палички під мікроскопом.
Як і де застосовується бактеріальна культура
До появи пробіотиків культури B. subtilis були популярні в усьому світі як імуностимулюючий засіб для лікування захворювань шлунково-кишкового тракту та сечовивідних шляхів. Користь сінної палички у її лікувальних складових. Сінна паличка використовувалася протягом 1950-х років як засіб альтернативної медицини для лікування проблем із травленням.
В даний час B. subtilis найчастіше застосовується як модельний організм у лабораторних дослідженнях, спрямованих на виявлення основних властивостей та характеристик грампозитивних спороутворюючих бактерій. Зокрема, багато принципів та механізмів, що лежать в основі утворення міцної ендоспори, були вивчені в результаті спостереження за процесом формування спор сенной палички.
Інші сучасні застосування B. subtilis наступні:
- її поверхнево-зв'язувальні властивості допомагають зробити утилізацію радіонуклідних відходів (особливо торію та плутонію) безпечною, з неї готують лікувальний сінний настій;
- завдяки відмінним ферментаційним властивостям та високому відсотку виходу продукту (від 20 до 25 грамів на 1 л) бактерія використовується для виробництва різних ферментів (таких як амілаза та деякі види протеази);
- як інокулянта ґрунту в садівництві та сільському господарстві;
- при виробництві шафрану як добриво, що прискорює зростання бульбоцибулин і збільшує вихід біомаси;
- як "індикаторний організм" під час процедур газової стерилізації, щоб гарантувати успішне завершення циклу.

